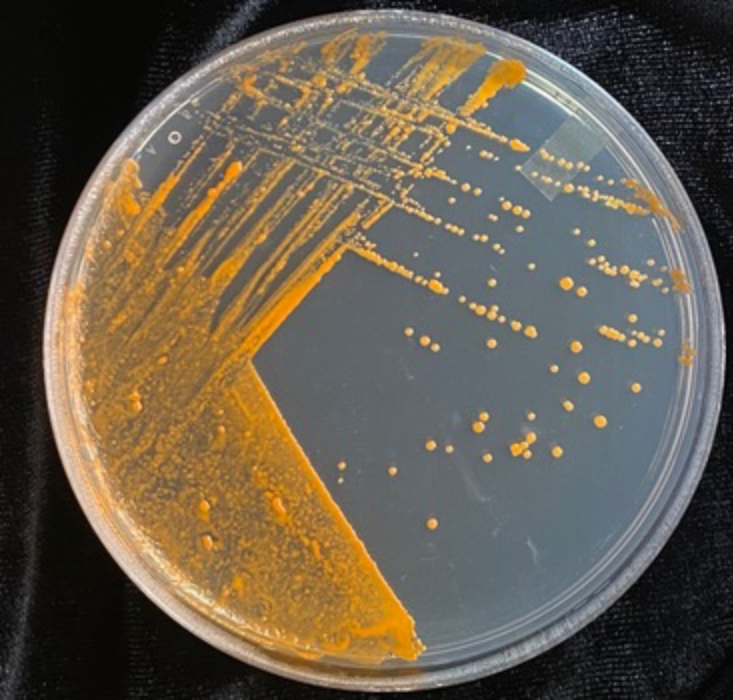
AA1NLmMO Kebakaran Hutan Merusak Anggur Favorit Anda. Bakteri Ini Mungkin Bisa Membantu

Kebakaran Hutan Merusak Anggur Favorit Anda. Bakteri Ini Mungkin Bisa Membantu
Ketika kebakaran hutan melanda landscape, mereka sering meninggalkan hutan yang terbakar, padang rumput, dan struktur buatan manusia di belakangnya. Namun bagi para pembuat anggur, api tidak biasanya menjadi sumber kekhawatiran terbesar – itu adalah asap, yang dapat menutupi kebun anggur dan memberikan rasa yang tidak menyenangkan, seperti abu, pada anggur yang dihasilkan.
Di tempat-tempat seperti California, Oregon, Washington, dan Australia—semua memiliki industri anggur yang kuat dan rentan terhadap kebakaran hutan—taint asap menjadi masalah besar. Hanya pada tahun 2020, perwakilan industri anggur Amerika memperkirakan bahwa taint asap dari kebakaran hutan di California yang mencatatkan rekor menyebabkan3,7 miliar dolardalam kerugian. Perubahan iklim, yang merupakanmemperkuat dan memperpanjangmusim kebakaran hutan, akan memperparah masalah tersebut.
Sekarang, para peneliti mengatakan mereka mungkin telah menemukan cara untuk mempertahankan anggur yang terkontaminasi asap. Bakteri yang ditemukan tumbuh pada tanaman anggur mungkin membantu menetralkan salah satu senyawa yang bertanggung jawab atas rasa yang tidak menyenangkan, mereka melaporkan pada 1 Oktober di jurnal tersebut.PLOS One.
Dalam eksperimen, para peneliti mengidentifikasi dua strain bakteriGordonia alkanivoransmampu memecah guaiakol, salah satu senyawa utama yang memberikan rasa asap yang tidak diinginkan pada anggur yang terkontaminasi kebakaran hutan. Mereka juga menemukan gen-gen dalam bakteri yang memberikan kemampuan super mereka untuk mengurai guaiakol.
Untuk penelitian ini, ilmuwan mengumpulkan daun dari tanaman anggur cabernet sauvignon dan chardonnay yang ditanam di rumah kaca di California. Para pengrajin anggur tidak secara sengaja menggunakan daun untuk membuat anggur, tetapi terkadang mereka dipanen secara tidak sengaja bersama buah anggur. Daun juga menyediakan luas permukaan yang besar bagi asap kebakaran hutan untuk menembus.
“Ketika Anda mengalami paparan asap, sebagian besar asap sebenarnya akan memengaruhi daun daripada buah,” co-author studiThomas Collins, seorang ahli kimia pertanian di Washington State University’s Wine Science Center, mengatakan kepadaIlmuwanAndrea Lius. “Dan ada bukti bahwa beberapa senyawa ini dapat berpindah dari daun ke buah.”
Para peneliti menumbuhkan delapan koloni bakteri dari bakteri yang ditemukan pada daun, lalu mengenalkan semuanya terhadap larutan guaiakol. Pada akhirnya, hanya dua strain dariG. alkanivoransmampu tumbuh dalam guaiakol, membentuk koloni berwarna jingga cerah di dalam cawan petri para peneliti. Bakteri lainnya mati.
Pengujian tambahan denganG. alkanivoranskadar kuman menunjukkan bahwa setelah 72 hingga 96 jam, bakteri telah hampir sepenuhnya menghilangkan guaiakol. Sementara itu, bakteri terus tumbuh dan berkembang biak, yang menunjukkan bahwa mereka mampu menggunakan guaiakol sebagai sumber makanan.
Tetapi guaiakol hanyalah salah satu senyawa volatil yang diketahui menyebabkan taint asap. Eksperimen dengan berbagai senyawa volatil tidak menunjukkan pertumbuhan bakteri, menunjukkan bahwa keduanyaG. alkanivoranskemungkinan besar merupakan spesialis guaiakol. Itu sedikit mengejutkan tim. “Masih ada ruang untuk mengevaluasi mengapa mereka begitu selektif,” kata Collins kepada.Ilmuwan.
Berdasarkan temuan ini, para peneliti kemungkinan akan perlu mengidentifikasi strain bakteri tambahan jika mereka berharap dapat mengatasi penyebab lain selain guaiakol. Tantangan lain yang mungkin harus diatasi:G. alkanivoransterlihat cukup langka. Setelah para peneliti menciptakan peristiwa “asap yang menyerupai kebakaran hutan” di lapangan yang penuh dengan tanaman merlot, mereka tidak dapat menemukan sama sekaliG. alkanivoranspada tanaman—teka-teki yang membingungkan, mengingat kecenderungan bakteri untuk menghabiskan guaiakol.
Namun, para ilmuwan tetap bersemangat dengan hasil mereka. Di masa depan, para pembuat anggur mungkin dapat memanfaatkan bakteri alami yang bermanfaat ini untuk mengatasi atau bahkan menghilangkan rasa asap pada anggur. Misalnya, para penenun anggur mungkin dapat mencegah guaiakol masuk ke dalam buah anggur sejak awal dengan menambahkan mikroba ke kebun anggur, menurutSainsCelina Zhao. Atau mungkin para peneliti dapat menghilangkan guaiacol dengan memasukkan bakteri ke dalam proses fermentasi.
Strategi proaktif jenis ini bahkan mungkin lebih efektif daripada teknik mitigasi rasa asap yang ada saat ini, seperti penyaringan anggur melalui arang aktif. Meskipun proses semacam itu menghilangkan rasa asap, mereka juga cenderung menghilangkan unsur-unsur yang lebih diinginkan, seperti warna yang cerah dan rasa halus anggur tersebut.
“pendekatan mikroba ini memiliki potensi untuk sedikit lebih spesifik tanpa memengaruhi kualitas keseluruhan anggur,” kataCole Cerrato, seorang ilmuwan makanan di Oregon State University yang tidak terlibat dalam penelitian tersebut, kepadaScienceNews‘ Carly Kay.
- Latihan Soal OSN Ilmu Komputer SMA 2026 - June 1, 2026
- Latihan Soal OSN Kebumian SMA 2026 - May 31, 2026
- Latihan Soal OSN Geografi SMA 2026 - May 30, 2026




Leave a Reply